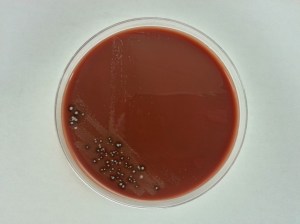
Cultures can also be innoculated onto chocolate agar. Notice the smaller grey colonies, which is the N. gonorrhoeae.  Notice the other colonies on the plate, as chocolate agar is not a selective medium.

A 22 year old male, treated for gonorrhea one month ago, presents with two days of dysuria and white penile discharge. He reported complete resolution of his symptoms with treatment. He has had sexual contact with 2 partners in the past month.
Cultures are taken and the following is seen on gram stain.

Seems like a clear cut case of gonorrhea, but given the patient’s history is this treatment failure, or likely reinfection?
The CDC has warned that rates of antibiotic resistant gonorrhea are on the rise. A once easily curable disease, is now becoming resistant to our mainstay treatment of ceftriaxone and azithromycin. Although cases have been reported, the majority of ‘failure of treatment’ scenarios are likely re-infection. Patients likely do not abstain until they are symptom free, or the partner may not be treated, leading to a reinfection of the patient. In the event of treatment failure, the CDC even recommends re-treating with the same ceftriaxone/azithromycin regiment. It is still recommended that a sample be taken for culture in the event that there is any concern over failure of treatment and possible antibiotic resistance.
Historically, testing for N. gonorrhoeae consisted of culture and gram stain, but the CDC now recommends testing for gonorrhea with nucleic acid amplification testing (NAAT). This test has improved sensitivity, less subjectivity and a much faster turnaround time than gram staining and culturing. It cannot, however, be used for test of cure, as the NAAT tests for DNA, which still may be present, even if the organisms have been killed within the host, leading to a false positive result.
When a clinician suspects gonorrhea, he or she should take care with what site the specimen is being collected from, and what sample is specifically needed. This lab is validated for only certain types of specimens, and it is important to communicate with the clinicians to ensure the proper specimens are being submitted.
The CDC states that the optimal samples should be vaginal swabs for women, and first catch urine for men. Great care should be used when collecting the ‘first catch urine’ as this is a dirty catch, and that some tests have specific requirements about quantity. For instance, at this lab, we require no more than 30 ml of urine. Any more volume could dilute the specimen which could cause a false negative result.
If a culture is required in the event of treatment failure, it is best if the clinician innoculates the sample directly onto Thayer Martin agar (or chocolate agar if that is all that is available). Given that N. gonorrhoeae is such a labile organism, it need special media to grow, and great care must be taken with transport. This lab recomends inoculating onto the Jembec plates (Thayer Martin media with a CO2 pellet) allowing survival during transport.

In conclusion, although the majority of cases of gonorrhea treatment failure are likely to be due to re-infection, antibiotic resistance is still of growing concern and clinicians should know when a culture is necessary for antibiotic sensitivity testing. N. gonorrhoeae requires nutrient supplementation for growth, either on Thayer Martin media, or chocolate agar. Care must be taken when sampling and transporting the specimen. Clinicians also need to be aware of the requirements for sample collection for NAATs, as it is not always clear as to why one can’t simply run a test on a sample greater than 30 ml, or a clean catch urine.
-Rich Smith is a Pathology Student Fellow at University of Vermont Medical Center.
-Christi Wojewoda, MD, is the Director of Clinical Microbiology at the University of Vermont Medical Center and an Assistant Professor at the University of Vermont.

I’m surprised the optimal sample for women is vaginal – would it not be cervical for NAAT? What type of analyzer does your lab use?
Hi, Krista–
For diagnosing genitourinary tract infections in females, the preferred specimen is a vaginal swab for NAAT testing and first stream urine in males. Culture is only recommended for potential treatment failure and in instances of child sexual assault in boys and extragenital infections in girls.
We currently use the Tigris instrument from Hologic.
–Dr. Wojewoda